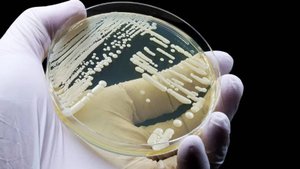

18:33
18:33
2024-11-14 20:06

 9:25
9:25

 9:25
9:25
2023-10-30 22:55

 12:40
12:40

 12:40
12:40
2023-11-17 01:51

 4:37
4:37

 4:37
4:37
2024-04-20 16:17

 3:24
3:24

 3:24
3:24
2023-12-22 00:48

 3:00
3:00

 3:00
3:00
2024-12-05 03:54

 5:04
5:04

 5:04
5:04
2024-10-05 15:20

 1:58
1:58

 1:58
1:58
2024-02-13 00:16

 3:08
3:08

 3:08
3:08
2025-05-13 01:06

 1:00
1:00

 1:00
1:00
2024-09-24 19:58

 0:32
0:32

 0:32
0:32
2023-12-28 23:06

 11:23
11:23

 11:23
11:23
2021-11-29 21:12

 2:34
2:34

 2:34
2:34
2023-09-17 09:12

 6:48
6:48

 6:48
6:48
2013-07-03 15:47

 1:13
1:13

 1:13
1:13
2020-04-30 10:30

 9:19
9:19

 9:19
9:19
МУКБАНГ АСМР КАША ПШЕННАЯ / КОЛБАСА ПОЛУКОПЧЕНАЯ / ЯИЧНИЦА / СОУС / СЛОЙКИ/ EATING ASMR Mukbang #518
2023-05-11 15:50
![[75hz] BLOODBATH BY RIOT 100% [EXTREME DEMON] | Dolphy](https://pic.rutubelist.ru/video/e3/6c/e36c6f882437ff17bf1072740a89d793.jpg?width=300)
 8:03
8:03
![[75hz] BLOODBATH BY RIOT 100% [EXTREME DEMON] | Dolphy](https://pic.rutubelist.ru/video/e3/6c/e36c6f882437ff17bf1072740a89d793.jpg?width=300)
 8:03
8:03
2024-01-01 11:54
![Железный Капут, но диктор - это Потолот [ТЕСТ]](https://pic.rutubelist.ru/video/56/a1/56a18055acc10e774119eff7e045c41f.jpg?width=300)
 0:56
0:56
![Ольга Стельмах – Кафе-Шантан (Премьера клипа 2025)]() 3:02
3:02
![Курбан Ожахлиев - Топи (Премьера клипа 2025)]() 2:52
2:52
![Александра Воробьева - Ход королевы (Премьера клипа 2025)]() 3:32
3:32
![DJ Serzh - Супружеский долг (Премьера клипа 2025)]() 3:53
3:53
![Премьера клипа! ХАБИБ - Шаганэ]() 2:49
2:49
![Антон и Альфия - Сентиментальный мотив (Премьера клипа 2025)]() 3:35
3:35
![W24 - I Gotta Feeling]() 3:49
3:49
![Эльдар Долаев - Ранила (Премьера клипа 2025)]() 3:02
3:02
![SEVENTEEN - For You SPECIAL VIDEO Live Clip]() 3:16
3:16
![Enrasta, Мурат Тхагалегов - Калым (Премьера клипа 2025)]() 3:07
3:07
![Джиган - Раз и навсегда (Премьера клипа 2025)]() 2:37
2:37
![Маша Кольцова - Дежавю (Премьера клипа 2025)]() 2:21
2:21
![Азамат Ражабов - Отам (Премьера клипа 2025)]() 4:38
4:38
![Лолита - 90-е]() 5:08
5:08
![TAEYONG - 501 Special Video]() 2:50
2:50
![Tural Everest, Руслан Добрый - Увидел во сне (Премьера клипа 2025)]() 2:22
2:22
![МС КАРАМЕЛЬКА - Найди меня]() 1:56
1:56
![Lx24 - Сберегу (Премьера клипа 2025)]() 2:57
2:57
![Толиб Тухтасинов - Хоп-Хоп (Премьера клипа 2025)]() 3:09
3:09
![Сергей Одинцов - Любимая, родная (Премьера клипа 2025)]() 3:32
3:32
![Богомол (2025) Netflix]() 1:53:25
1:53:25
![Тот самый | Him (2025)]() 1:36:20
1:36:20
![Монстры: История Эда Гейна (2025) (мини-сериал)]() 7:26:60
7:26:60
![Добыча (2022)]() 1:45:08
1:45:08
![Стив (2025)]() 1:33:30
1:33:30
![Плохой Cанта 2 | Bad Santa 2 (2016) (Гоблин)]() 1:28:32
1:28:32
![Все дьяволы здесь (2025)]() 1:31:30
1:31:30
![Только ты | All of You (2025)]() 1:38:22
1:38:22
![Военнопленный (2025)]() 1:52:52
1:52:52
![Девушка из каюты №10 (2025)]() 1:35:13
1:35:13
![Чумовая пятница (2003)]() 1:36:57
1:36:57
![Скандальный взлом (2019)]() 1:54:14
1:54:14
![Как бы беременна (2025) Netflix]() 1:40:02
1:40:02
![Французский любовник | French Lover (2025)]() 2:02:20
2:02:20
![Миссия невыполнима: Финальная расплата (2025)]() 2:52:55
2:52:55
![не14]() 1:32:52
1:32:52
![Волынь (2016)]() 2:28:56
2:28:56
![Вивариум (2019)]() 1:38:34
1:38:34
![Код 3 (2025)]() 1:39:52
1:39:52
![Финикийская схема (2025)]() 1:41:00
1:41:00
![Земля до начала времён 9: Путешествие к Большой Воде (2002) / The Land Before Time IX]()
 1:14:38
1:14:38
![Альфа и Омега 2: Приключения праздничного воя (2013) / Alpha and Omega 2: A Howl-iday Adventure]()
 45:08
45:08
![Иллюзионист (2010) / L'illusionniste]()
 1:19:53
1:19:53
![Барби: Виртуальный мир (2017) / Barbie Video Game Hero]()
 1:12:19
1:12:19
![Эти прекрасные мультяшки: Рождественский выпуск (1992) / It's a Wonderful Christmas Special]()
 22:22
22:22
![Упс… Ной уплыл! (2015) / Ooops! Noah Is Gone...]()
 1:26:28
1:26:28
![Девочки из Эквестрии. Легенды вечнозелёного леса (2016) / Equestria Girls. Legend of Everfree]()
 1:13:14
1:13:14
![Альфа и Омега: Клыкастая братва (2010) / Alpha and Omega]()
 1:27:56
1:27:56
![Барби и её сёстры в поисках щенков (2016) / Barbie & Her Sisters in a Puppy Chase]()
 1:15:20
1:15:20
![Сказки Серого Волка (2016) / Revolting Rhymes]()
 58:58
58:58
![Науэль и волшебная книга (2020) / Nauel and the Magic Book]()
 1:37:06
1:37:06
![Земля до начала времён 2: Приключения в Великой Долине (1994) / The Land Before Time II]()
 1:13:31
1:13:31
![Лоракс (2012) / The Lorax]()
 1:26:13
1:26:13
![Альфа и Омега 4: Легенда о Зубастой Пещере (2014) / Alpha and Omega 4]()
 45:14
45:14
![Земля до начала времён 3: В поисках воды (1995) / The Land Before Time III]()
 1:10:48
1:10:48
![Земля до начала времён 6: Тайна Скалы Динозавров (1998) / The Land Before Time VI]()
 1:12:60
1:12:60
![Земля до начала времён 10: Великая миграция (2003) / The Land Before Time X]()
 1:24:21
1:24:21
![Шерлок Гномс (2018) / Sherlock Gnomes]()
 1:26:19
1:26:19
![Волшебный парк Джун (2019) / Wonder Park]()
 1:25:17
1:25:17
![Земля до начала времён 12: Великий День птиц (2006) / The Land Before Time XII]()
 1:20:30
1:20:30
![Железный Капут, но диктор - это Потолот [ТЕСТ]](https://pic.rutubelist.ru/video/56/a1/56a18055acc10e774119eff7e045c41f.jpg?width=300)
 0:56
0:56Скачать видео
| 256x144 | ||
| 426x240 | ||
| 640x360 | ||
| 854x480 | ||
| 1280x720 | ||
| 1920x1080 |
 3:02
3:02
2025-10-11 11:50
 2:52
2:52
2025-10-11 12:23
 3:32
3:32
2025-10-11 12:12
 3:53
3:53
2025-10-06 10:58
 2:49
2:49
2025-10-10 09:59
 3:35
3:35
2025-10-09 09:15
2025-10-12 18:28
 3:02
3:02
2025-10-10 12:56
2025-10-09 18:00
 3:07
3:07
2025-10-11 12:03
 2:37
2:37
2025-10-10 12:33
 2:21
2:21
2025-10-07 14:25
 4:38
4:38
2025-10-11 12:52
2025-10-05 18:36
2025-10-08 16:00
 2:22
2:22
2025-10-07 11:25
2025-10-05 18:34
 2:57
2:57
2025-10-11 12:26
 3:09
3:09
2025-10-11 21:54
 3:32
3:32
2025-10-07 11:46
0/0
 1:53:25
1:53:25
2025-09-28 20:47
 1:36:20
1:36:20
2025-10-09 20:02
 7:26:60
7:26:60
2025-10-05 20:29
 1:45:08
1:45:08
2025-10-06 12:51
 1:33:30
1:33:30
2025-10-05 21:21
 1:28:32
1:28:32
2025-10-07 09:27
 1:31:30
1:31:30
2025-09-30 19:30
 1:38:22
1:38:22
2025-10-01 12:16
 1:52:52
1:52:52
2025-09-29 17:31
 1:35:13
1:35:13
2025-10-12 11:54
 1:36:57
1:36:57
2025-09-28 17:49
 1:54:14
1:54:14
2025-10-01 18:56
 1:40:02
1:40:02
2025-10-08 19:42
 2:02:20
2:02:20
2025-10-01 12:06
 2:52:55
2:52:55
2025-10-05 20:57
2025-10-13 04:45
 2:28:56
2:28:56
2025-10-08 21:04
 1:38:34
1:38:34
2025-10-01 13:01
 1:39:52
1:39:52
2025-10-05 17:25
 1:41:00
1:41:00
2025-10-05 21:22
0/0

 1:14:38
1:14:38
2025-09-28 18:00

 45:08
45:08
2025-10-08 18:00

 1:19:53
1:19:53
2025-10-11 18:00

 1:12:19
1:12:19
2025-09-05 18:00

 22:22
22:22
2025-09-11 18:00

 1:26:28
1:26:28
2025-09-06 18:00

 1:13:14
1:13:14
2025-10-01 18:00

 1:27:56
1:27:56
2025-09-16 18:00

 1:15:20
1:15:20
2025-09-03 18:00

 58:58
58:58
2025-09-02 18:00

 1:37:06
1:37:06
2025-10-05 18:00

 1:13:31
1:13:31
2025-09-13 18:00

 1:26:13
1:26:13
2025-09-14 18:00

 45:14
45:14
2025-10-12 18:00

 1:10:48
1:10:48
2025-09-15 18:00

 1:12:60
1:12:60
2025-09-22 18:01

 1:24:21
1:24:21
2025-09-30 18:00

 1:26:19
1:26:19
2025-09-25 18:00

 1:25:17
1:25:17
2025-09-08 18:00

 1:20:30
1:20:30
2025-10-04 18:00
0/0